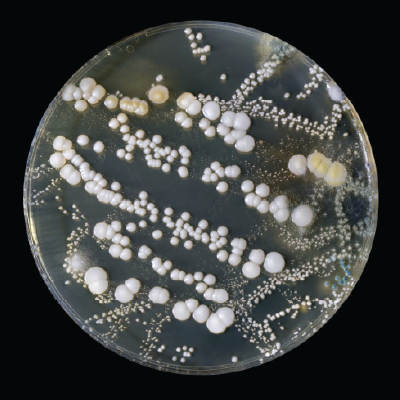

Translate
Microbial Growth Prevention & Reporting
About Spores
Microbial growth is a type of fungus—yeast, mushrooms or similar organisms that occurs everywhere.
It grows indoors and outdoors in spots that are warm and damp and exposed to oxygen and food—organic matter. Bathrooms, kitchens, and basements are especially good breeding grounds.
Spores enter through open doors, windows, vents, and HVAC systems. They also hitch a ride indoors on clothing, shoes, bags, and even pets.
If left untreated spores can grow on many common building materials, including paper, cardboard, ceiling tiles, and wood. They also thrive in dust, paint, wallpaper, insulation, drywall, carpet, fabric, and upholstery.
Prevention
While we can't completely be rid of spores—they're always present in the air—we can take steps to prevent it and clean it.To stop microbial growth from actively growing, control moisture and indoor humidity.
- Keep living spaces clean and dry.
- Prevent moisture condensation.
- Maintain indoor relative humidity at low levels
- Vent moisture-generating appliances to the outside.
When to Act
If you suspect or see visible microbial growth, submit a work order request in your Housing Portal on MyCalPoly or call 805-756-1587. Provide as much information as possible. Describe the concern in detail, e.g. visible growth on wall. Indicate if there is standing water, wet or damp walls/floors, or leak. Add your contact info. and the building and room number.
Remediation
If the area of microbial growth is less than 10 sq. ft, remediation and cleaning efforts will be addressed by trained housing facilities staff.The area is disinfected and HEPA vacuumed to remove spores.
Third-party remediation professionals are brought in to conduct cleaning of larger spaces. If the humidity in the space needs to be lowered, industrial dehumidifiers are installed, and the space is monitored to ensure the humidity stays within an acceptable range.
When water intrusion is identified during the assessment, a work request will be initiated with FMD to schedule a repair.


